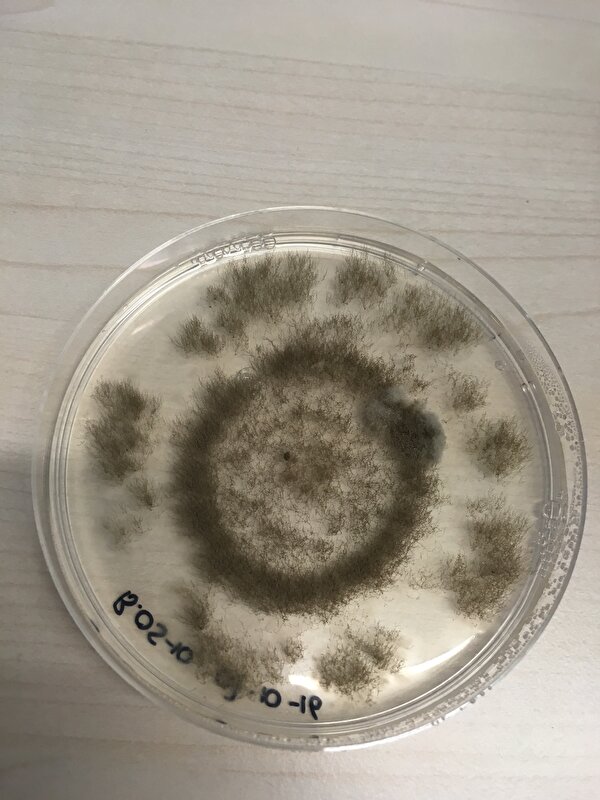
Afbeelding

Het is blijkbaar overerfbaar, mijn vader, nicht en tante ook.
Moderators: NadjaNadja, Essie73, Muiz, Polly, Telpeva, ynskek
Votti schreef:Ik meld me! Heb 6 jaar geleden de HLO opleiding afgerond, daarna 5 jaar gewerkt als research analist in het pathologie lab in Rotterdam, en nu aan de slag als PhD! Vind het labwerk echt heerlijk, zo fijn om lekker te pipetteren
Votti schreef:Ik meld me! Heb 6 jaar geleden de HLO opleiding afgerond, daarna 5 jaar gewerkt als research analist in het pathologie lab in Rotterdam, en nu aan de slag als PhD! Vind het labwerk echt heerlijk, zo fijn om lekker te pipetteren
Votti schreef:Lollieloes, ik merkte dat ik meer aankon dan er van mijn functie gevraagd werd. Ik heb toen twee publicaties als eerste auteur gepubliceerd en met mijn baas overlegd wat er mogelijk was. Ik kom origineel ook van het VWO, heb juist HLO gedaan omdat ik het praktische werk geweldig vind, maar wil wel graag de kennis die ik heb (en nog ga opdoen) nu voor een hogere functie gebruiken.

Joanieke schreef:Iemand hier verstand van Botrytis?
Ik had op stage deze platen, mijn eerste gedachte was contaminatie, maar ik heb dit op meerdere platen gezien, ook op platen die de eerste weken 'steriel' leken te zijn groeide na een tijd deze structuren.. Ik weet dus alleen niet hoe ik deze structuren moet noemen..
[ [url=m/RwNBwa.jpg]Afbeelding[/url] ]
De plek onder de binoculair, het witte is zeg maar de plek die op de plaat grijs is.. Ik zag hier verder ook geen sporen, enkel witte draden..
[ [url=m/kNevEG.jpg]Afbeelding[/url] ]
Votti schreef:Waar bewaar je je platen, t zijn gewone agar bodems dit toch? Kan zijn dat bijvoorbeeld je koelkast besmet is, waardoor er na verloop van tijd lekker schimmel op gaat groeien. Zit er nog selectie op de platen (ampicilline oid)?
Lolllieloes, ik doe in principe nog precies hetzelfde werk, maar dan met een andere functie. Het enige dat er voor mij veranderd is, is dat ik onderwijs moet geven (bleuh..) en dat ik nu een extra database artikel mag schrijven. Ik sta nog steeds lekker in het lab te western blotten bijvoorbeeld
corientjuhh schreef:Op school moesten we t altijd zelf maken.
Toch weer een domper als ze toch besmet waren kon je weer opnieuw![]()
Vond MiBi altijd erg leuk om te doen, maar die richting hadden we niet op school helaas.



